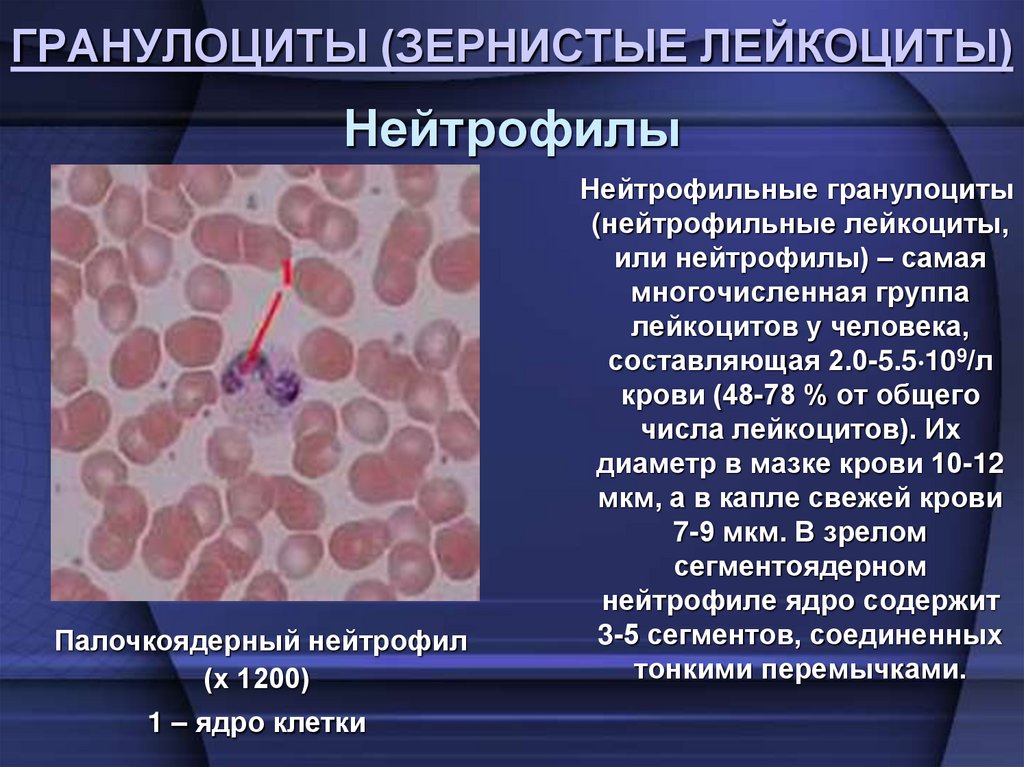
ГРАНУЛОЦИТЫ (ЗЕРНИСТЫЕ ЛЕЙКОЦИТЫ)
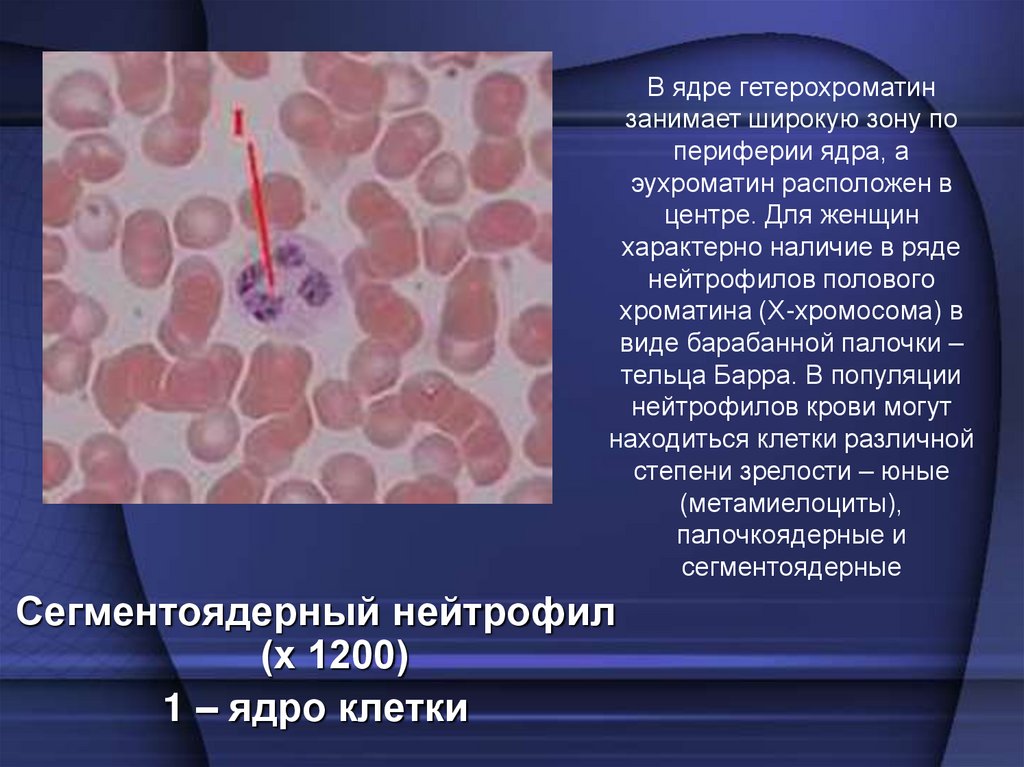
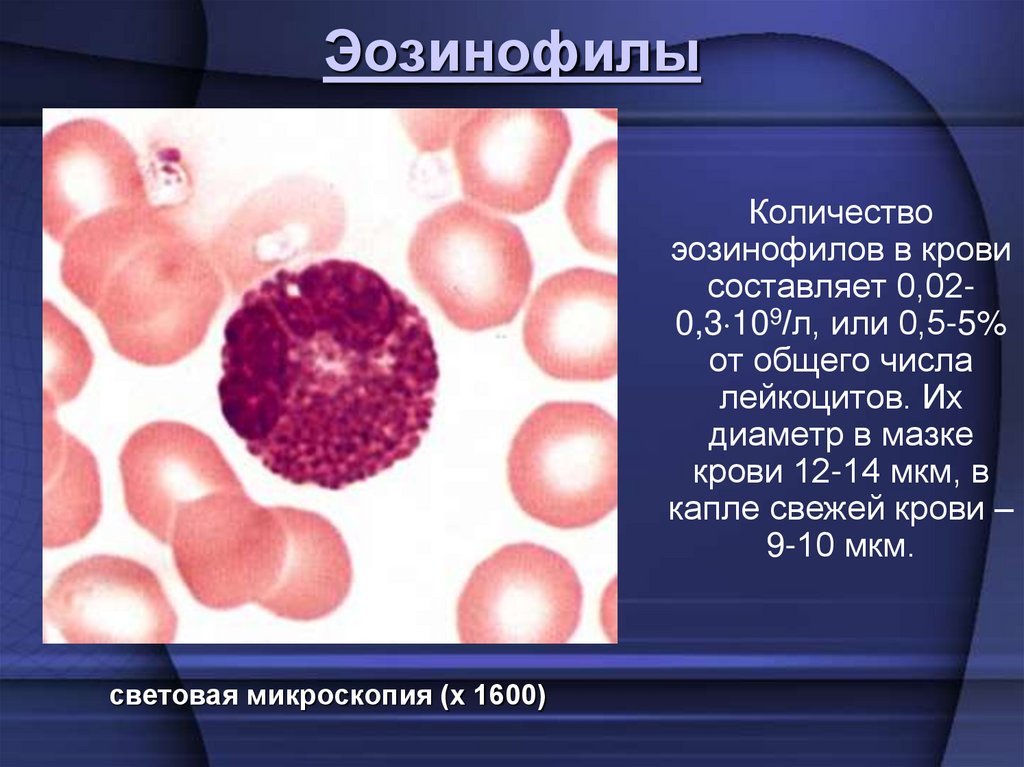
Эозинофилы

Similar presentations:
Кровь
1.
Кровь и лимфаявляются основными
разновидностями тканей
мезенхемального
происхождения,
образующими вместе с
рыхлой волокнистой
соединительной тканью
внутреннюю среду
организма.
2. Функции крови:
Транспортная – перенос различных веществ.
Дыхательная – перенос кислорода и углекислого газа.
Трофическая – перенос питательных веществ.
Экскреторная – выведение из организма различных шлаков,
образующихся в процессе его жизнедеятельности.
Гуморальная – транспорт гормонов и других биологически
активных веществ.
Гомеостатическая – поддержание постоянства внутренней
среды организма.
Теплорегулирующая – перенос тепла из глубоколежащих
органов к поверхности для его рассеяния (что существенно для
крупных животных с высокой интенсивностью обмена веществ).
Защитная – обеспечение гуморального и клеточного иммунитета,
способность к свертыванию.
Передача механической силы (например, для локомоции у
дождевых червей; для разрыва кутикулы при линьке у ракообразных;
для движения таких органов, как сифон двустворчатых моллюсков и
т.п.; для разгибания ног у пауков; для ультрафильтрации в
капиллярах почек).
3. Состав крови
КровьПлазма
Клеточные элементы
Эритроциты
Лейкоциты
Тромбоциты
4. Гематокритное число - соотношение объемов плазмы и клеточных элементов крови. А – свежая кровь; Б – полное разделение на плазму
Гематокритное число соотношение объемовплазмы и клеточных
элементов крови.
А – свежая кровь;
Б – полное разделение на
плазму и клеточные
элементы.
5. Состав плазмы крови
• Вода – 90-92 %• Неорганические компоненты: ионы калия,
натрия, кальция, магния, хлора и т.д.
• Сухой остаток – 8-10%, в том числе белки –
60-80 г/л
• Небелковые вещества: аминокислоты,
мочевина, мочевая кислота, глюкоза, липиды
(холестерин, триглицериды и т.д.)
6. БЕЛКИ ПЛАЗМЫ
КОНЦЕНТРАЦИЯВ ПЛАЗМЕ, Г/Л
ОСНОВНЫЕ ФУНКЦИИ
35 - 40
Онкотическое давление, транспорт
Са2+, жирных кислот и других
липофильных веществ
α1-глобулины
3-6
Транспорт липидов, тироксина,
гормонов коры надпочечников.
Ингибитор трипсина и
химотрипсина
α 2-лобулины
4-9
Ингибитор плазмина. Связывание
свободного гемоглобина
β-глобулины
6 - 11
Транспорт липидов, железа. Белки
системы комплемента
γ-глобулины
13 - 17
Циркулирующие антитела
Фибриноген
30
Свертывание крови, агрегация
тромбоцитов
Протромбин
1
Свертывание крови
БЕЛКИ
Альбумин
7. Эритроциты
представляют собой безъядерные двояковогнутые клетки,утратившие в процессе фило- и онтогенеза ядро и большинство
органелл. Эритроциты являются высокодифференцированными
постклеточными структурами, неспособными к делению.
Количество эритроцитов у взрослого мужчины составляет
3,9-5,5 1012/л, а у женщин — 3,7-4,9 1012/л крови. Однако число
эритроцитов у здоровых людей может варьировать в зависимости
от возраста, эмоциональной и мышечной нагрузки, действия
экологических факторов и др.
микрофотография.
Эритроциты в
мазке крови
человек (х 1200)
сканирующая
электронная
микроскопия
(х 3300)
сканирующая
электронная
микроскопия
(х 4000)
монетные столбики
(х 900)
8. эритроциты в поврежденном сосуде (х 2400)
9. Расположение эритроцитов в капилляре
(х 6000)(х 2850)
(х 4800)
высокая электронная
плотность цитоплазмы
эритроцита (темная
окраска) обусловлена
присутствием железа в
молекуле гемоглобина)
10.
Плазмолемма эритроцита состоит избислоя липидов и белков,
представленных приблизительно в
равных количествах, а также
небольшого количества углеводов,
формирующих гликокаликс.
Большинство липидных молекул,
содержащих холин (фосфатидилхолин,
сфингомиелин), расположены во
внешнем слое плазмолеммы, а липиды,
несущие на конце аминогруппу
(фосфатидилсерин,
фосфатидилэтаноламин), лежат во
внутреннем слое.
Часть липидов (~ 5%) наружного
слоя соединены с молекулами
олигосахаров и называются
гликолипидами.
Распространены мембранные
гликопротеины – гликофорины. С
А – схема: 1 – плазмолемма; 2 – белок полосы 3; 3 – гликофорин
ними связывают антигенные различия спектрин (альфа- и бетта цепи); 5 – анкирин; 6 – белок полосы 4.
– узловой комплекс; 8 – актин.
между группами крови человека.
Б – плазмолемма и цитоскелет эритроцита в сканирующем
электронном микроскопе. 1 – плазмолемма; 2 – сеть спектрина
11.
• Гемоглобин — это сложный белок (68 КД), состоящий из 4полипептидных цепей глобина и гема (железосодержащий
порфирин), обладающий высокой способностью связывать
кислород.
• В норме у человека содержится два типа гемоглобина –
НbА и HbF. Эти гемоглобины различаются составом
аминокислот в глобиновой (белковой) части. У взрослых
людей в эритроцитах преобладает НbА, (от англ. adult —
взрослый), составляя 98 %. HbF или фетальный гемоглобин
(от англ. foetus — плод) составляет у взрослых около 2 % и
преобладает у плодов. К моменту рождения ребенка HbF
составляет около 80 %, а НbА только 20 %. Эти
гемоглобины отличаются составом аминокислот в
глобиновой (белковой) части. Железо (Fe2+) в геме может
присоединять О2 в легких (в таких случаях образуется
оксигемоглобин — НbО2) и отдавать его в тканях путем
диссоциации НbО2 на кислород (О2) и Нb; валентность Fe2+
не изменяется.
12. Патология
слипшиесяэритроциты
серповидно-клеточная анемия
В настоящее время выявлено более 150 видов аномальных гемоглобинов. Например,
при серповидно-клеточной анемии имеет место генетически обусловленное повреждение
в бетта-цепи гемоглобина – глютаминовая кислота заменена на аминокислоту валин.
Такой гемоглобин обозначается как HbS (от англ. sickle — серп), так как в условиях
понижения парциального давления О2 он превращается в тектоидное тело, придавая
эритроциту форму серпа.
В ряде стран тропического пояса определенный контингент людей являются
гетерозиготными для серповидных генов, а дети двух гетерозиготных родителей по
законам наследственности дают либо нормальный тип (25%), либо бывают
гетерозиготными носителями, и 25% страдают серповидно-клеточной анемией.
13. Функции эритроцитов
Дыхательная функция - транспорт О2, СО2.Транспортная функция - транспорт белков,
полипептидов.
Буферная функция - обеспечение кислотнощелочного равновесия, благодаря гемоглобиновой
буферной системе.
Поддержание реологических свойств крови в
частности вязкости. При увеличении числа
эритроцитов вязкость возрастает и наоборот.
Обеспечение групповых свойств крови.
Участие в регуляции водно-солевого обмена,
благодаря способности адсорбировать на
поверхности воду и ионы.
Принимают участие в свертывании крови, т.к.
содержат эритроцитарные факторы свертывания.
14.
15. Лейкоциты
Лейкоциты, или белые кровяные клетки, в свежей крови бесцветны, чтоотличает их от окрашенных эритроцитов. Число их составляет в среднем
4-9 109/л.
Увеличение числа лейкоцитов – лейкоцитоз, уменьшение – лейкопения.
Лейкоциты
Зернистые
(гранулоциты)
Нейтрофилы
49-79 %
Эозинофилы
0,5-5 %
Незернистые
(агранулоциты)
Базофилы
0-1 %
Лимфоциты
19-37 %
Моноциты
3-11 %
16. ГРАНУЛОЦИТЫ (ЗЕРНИСТЫЕ ЛЕЙКОЦИТЫ)
НейтрофилыПалочкоядерный нейтрофил
(х 1200)
1 – ядро клетки
Нейтрофильные гранулоциты
(нейтрофильные лейкоциты,
или нейтрофилы) – самая
многочисленная группа
лейкоцитов у человека,
составляющая 2.0-5.5 109/л
крови (48-78 % от общего
числа лейкоцитов). Их
диаметр в мазке крови 10-12
мкм, а в капле свежей крови
7-9 мкм. В зрелом
сегментоядерном
нейтрофиле ядро содержит
3-5 сегментов, соединенных
тонкими перемычками.
17.
В ядре гетерохроматинзанимает широкую зону по
периферии ядра, а
эухроматин расположен в
центре. Для женщин
характерно наличие в ряде
нейтрофилов полового
хроматина (Х-хромосома) в
виде барабанной палочки –
тельца Барра. В популяции
нейтрофилов крови могут
находиться клетки различной
степени зрелости – юные
(метамиелоциты),
палочкоядерные и
сегментоядерные
Сегментоядерный нейтрофил
(х 1200)
1 – ядро клетки
18.
Сегментоядерные нейтрофилы периферическойкрови человека (х 2400)
19. Гистологическая реакция на щелочную фосфатазу (х 800)
20. Нейтрофилы периферической крови человека. D – половой хроматин
(х 1 200)(х 2 400)
Нейтрофилы периферической крови человека.
D – половой хроматин
Для женщин характерно наличие в ряде нейтрофилов полового
хроматина (Х-хромосома) в виде барабанной палочки – тельца Барра.
21.
электроннаямикрофотография
Нейтрофила
(х 10 000)
В нейтрофилах можно различить два типа гранул: специфические и
азурофильные, окруженные одинарной мембраной Ядро нейтрофила состоит
из 5 сегментов. В них хроматин конденсирован – что является признаком
низкой синтетический активности белка. В цитоплазме множество гранул.
Первичные гранулы (Р) – сферической формы электронно-плотные аналогичны
лизосомам. Преобладают вторичные гранулы (S), – более мелкие,
разнообразной формы и электронной плотности.
22.
Функции нейтрофиловСпособность к фагоцитозу.
Разрушение и переваривание
поврежденных клеток и тканей
(нейтрофилы обычно первыми
прибывают в очаг повреждения).
Участие в регуляции деятельности
других клеток (благодаря
способности нейтрофилов к
выработке ряда цитокинов).
23.
• В популяции нейтрофилов здоровыхлюдей в возрасте 18-45 лет
фагоцитирующие клетки составляют
69-99%. Этот показатель называют
фагоцитарной активностью.
Фагоцитарный индекс – показатель,
которым оценивается число частиц,
поглощенных одной клеткой. Для
нейтрофилов он равен 12-23.
Продолжительность жизни
нейтрофилов составляет 5-9 суток.
24. Эозинофилы
Количествоэозинофилов в крови
составляет 0,020,3 109/л, или 0,5-5%
от общего числа
лейкоцитов. Их
диаметр в мазке
крови 12-14 мкм, в
капле свежей крови –
9-10 мкм.
световая микроскопия (х 1600)
25. сканирующая электронная микрофотография (х 20 000)
Ядро эозинофилов имеет, какправило, 2 сегмента, соединенных
перемычкой.
В цитоплазме расположены
органеллы: аппарат Гольджи (около
ядра), немногочисленные
митохондрии, актиновые
филаменты в кортексе цитоплазмы
под плазмолеммой и гранулы.
Среди гранул различают
азурофильные (первичные) и
эозинофильные (вторичные),
являющиеся модифицированными
лизосомами.
сканирующая электронная
микрофотография (х 20 000)
Электронно-микроскопически в
экваториальной плоскости
эозинофильных гранул выявляются
единичные или множественные
кристаллоидные структуры,
имеющие пластинчатое строение,
погруженные в тонкозернистый
матрикс гранулы. Кристаллоиды
эозинофильных гранул содержат
основной белок, который участвует
в антипаразитарной функции
эозинофилов.
26. Эозинофилы крови. Электронная микроскопия (х25 000). S – специфические гранулы эозинофилов овальной формы, содержащие
Эозинофилы крови. Электронная микроскопия (х25 000).S – специфические гранулы эозинофилов овальной формы,
содержащие кристаллоподобные структуры различной формы,
низкой электронной плотности
27.
Функции эозинофиловПоглощение гистамина.
Противоглистный иммунитет,
или цитотоксический эффект.
Предупреждение проникновения
антигена в сосудистое русло.
Уменьшение реакции ГНТ
(гиперчувствительности
немедленного типа).
28.
• Таким образом, эозинофилы являются первой линиейзащиты против паразитов. Они участвуют в убийстве
этих агентов при выделении содержимого гранул после
активации антителами и комплементом.
• Эозинофилы находятся в периферической крови менее
12 часов и потом переходят в ткани. Их мишенями
являются такие органы, как кожа, легкие и
гастроинтестинальный тракт.
• Изменение содержания эозинофилов может
наблюдаться под действием медиаторов и гормонов:
например, при стресс-реакции отмечается падение
числа эозинофилов в крови, обусловленное
увеличением содержания гормонов надпочечников.
29.
БазофилыБазофильные
гранулоциты
(базофильные
лейкоциты, или
базофилы). Количество
базофилов в крови
составляет 0-0,06 109/л,
или 0-1 % от общего
числа лейкоцитов. Их
диаметр в мазке крови
равен 11-12 мкм, в
капле свежей крови –
около 9 мкм.
световая микроскопия (х 1 800)
30.
Ядро обычно двухлопастное,часто цитоплазма заполнена
крупными базофильными
гранулами.
Электронная
фотография
эозинофила мыши
N – двухлопасное ядро;
S - кристаллические структуры в
гранулах эозинофилов мыши
имеют
более
высокую
электронную плотность; sER –
гладкий эндоплазматический
ретикулум; rER – шероховатый
эндоплазматический
ретикулум;
SER
эндоплазматический
ретикулум; R – рибосомы; М –
митохондрии.
31.
Функции базофиловочищение среды от биологически активных
веществ путем их поглощения;
синтез и выделение в среду БАВ-регуляторов
физиологических процессов ( гепарин, гистамин,
серотонин);
регуляция микроциркуляции (локального
кровотока) за счет выделения БАВ;
регуляция проницаемости капилляров за счет ее
активации гистамином и серотонином и снижения
проницаемости при выделении гепарина;
активация процесса пролиферации клеток тканей;
участие в механизмах иммунных реакций, в том
числе в реакциях клеточного иммунитета
совместно с макрофагами и нейтрофиламифагоцитами.
32.
АГРАНУЛОЦИТЫ(НЕЗЕРНИСТЫЕ ЛЕЙКОЦИТЫ)
малый лимфоцит средний лимфоцит
(х 1200)
(х 1200)
моноцит
(х 1200)
33.
сканирующая электронная микроскопия:В-лимфоцит
(х 18 000)
Т-лимфоцит
(х 16 000)
моноцит
(х 19 000)
34. Морфологические особенности лимфоцитов
ПараметрыЛимфоциты
По размеру лимфоциты делятся на:
Размер клеток
•малые лимфоциты (диаметром 4,5-6 мкм),
•средние (диаметром 7-10 мкм),
•большие (диаметром 10 мкм и более)
Форма и окраска
ядра
Ядро – круглое, гиперхромное (сильно
окрашенное)
Цитоплазма
Цитоплазма составляет лишь узкий
ободок вокруг ядра, базофильна и не
содержит гранул
35.
Морфологические особенностимоноцитов
Параметры
Моноциты
Размер клеток
Моноциты - значительно крупнее:
в мазке, распластываясь по стеклу,
имеют в диаметре 18-20 мкм
Форма и
окраска ядра
Ядро - бобовидное или
подковообразное, светлое
Цитоплазма
Цитоплазма составляет заметную часть
клетки, менее базофильна и возле ядра
может содержать несколько гранул
36.
ЛимфоцитыВ крови взрослых людей они составляют 20-35% от
общего числа лейкоцитов (1,0-4,0 109/л).
средний
лимфоцит
(х 1 200)
малый
лимфоцит
(х 1 200)
В-лимфоцит
(х 19 000)
сканирующая
электронная
микроскопия
(х 20 000)
Т-лимфоцит
(х 16 000)
37. лимфоциты в мазке периферической крови (х 800)
сканирующаяэлектронная
микроскопия (х 15 000)
38. Классификация лимфоцитов по функциональному признаку
Видылимфоцитов
Относительное
содержание (%)
Абсолютное
содержание
(клеток/л)
Т-лимфоциты
70-80
(0,7-2,4) х 109
В-лимфоциты
10-12
(0,1-0,6) х 109
39. Функциональные популяции лимфоцитов
Влимфоцитыа) В процессе иммунного ответа (т.е. в ответ на антигенную
стимуляцию) В-лимфоциты превращаются в тканях в плазматические
клетки (плазмоциты), активно синтезирующие специфические
антитела.
б) Последние связываются либо с растворимыми антигенами (после
чего образовавшиеся комплексы фагоцитируются нейтрофилами),
либо с антигенами на поверхности клеток (что приводит, в конечном
счёте, к разрушению этих клеток).
Т-хелперы
Тлимфоциты
(тимусзависи
мые клетки)
а) Название – от англ. to help (помогать).
б) Т-хелперы тоже взаимодействуют с антигенами и,
вырабатывая ряд стимуляторов, резко активизируют
иммунный ответ В-клеток.
Т-супрессоры
оказывают
противоположное
Т(сдерживающее) влияние на иммунный ответ, чтобы он
супрессоры
не достигал чрезмерной силы.
Т-киллеры
а) Название – от англ. to kill (убивать).
б) Узнавая чужеродные клетки, Т-киллеры разрушают
их, выделяя вещества, лизирующие плазмолемму.
в)
Обломки
же
последних
фагоцитируются
макрофагами (происходящими, как отмечалось, из
моноцитов).
40. В капле свежей крови моноциты лишь немного крупнее других лейкоцитов (9-12 мкм), количество их колеблется в пределах 6-8% от
МоноцитыВ капле свежей крови моноциты лишь немного крупнее
других лейкоцитов (9-12 мкм), количество их колеблется
в пределах 6-8% от общего числа лейкоцитов.
моноцит в
периферической
крови (х 1 000)
моноцит в
периферической
крови (х 1 000)
электронная микроскопия
(х 22 000)
41.
Функции моноцитовСпособность к фагоцитозу.
Секреторная функция — продуцируются лизоцим,
активные формы кислорода, интерлейкин-I.
Цитотоксическая функция — повреждение клетокмишеней (противоопухолевый, противопаразитарный,
противомикробный и противовирусный иммунитет).
Участие в процессах резорбции тканей, например, в
процессах инволюции желтого тела яичников,
послеродовой матки, молочных желез после лактации.
Стимуляция пролиферативных процессов, в частности
пролиферации гладкомышечных клеток в сосудах.
Участие в регуляции углеводного и липидного обменов.
Участие в механизмах специфического иммунитета — в
процессах кооперации Т- и В-лимфоцитов. Этот
процесс носит название презентации антигена. Кроме
того, моноциты вырабатывают монокины, которые могут
усиливать или, наоборот, тормозить иммунный ответ со
стороны Т- и В-лимфоцитов (интерлейкины – I).
42.
43. Кровяные пластинки, тромбоциты, в свежей крови человека имеют вид мелких бесцветных телец округлой, овальной или веретеновидной
ТромбоцитыКровяные пластинки, тромбоциты, в свежей крови человека имеют
вид мелких бесцветных телец округлой, овальной или
веретеновидной формы размером 2-4 мкм. Количество их в крови
человека колеблется от 2,0 109/л до 4,0 109/л
световая
микроскопия
(х 1 600)
сканирующая
электронная
микроскопия
(х 18 000)
световая
микроскопия
(х 1 800)
44.
Функции тромбоцитовУчастие в процессе свертывания крови,
за счет содержащихся в тромбоцитах 12
факторов свертывания.
Участие в метаболизме серотонина.
Тромбоциты – это практически
единственные элементы крови, в
которых из плазмы накапливаются
резервы серотонина.
45. Характеристика форменных элементов крови по их основным функциям и продуктами синтетической деятельности
Форменные элементыкрови
Основные функции
Продукты синтеза
Эритроциты
Транспорт кислорода
Гемоглобин
Нейтрофилы
Фагоцитоз бактерий
Специфические гранулы и лизосомы
(азурофильные гранулы)
Эозинофилы
Защита от гельминтов; модуляция
воспалительных и
аллергических процессов
Специфические гранулы, биологически
активные вещества
Базофилы
Освобождение гистамина и других
медиаторов воспаления
Специфические гранулы, которые содержат
гистамин и гепарин
Моноциты
Превращение в клетки макрофаговой
системы в тканях; фагоцитоз
простейших, вирусов, клеток
организма, которые стареют
Гранулы, которые содержат лизосомные
ферменты
В-лимфоциты
Превращение в
антителопродуцирующие клетки
(плазмоциты)
Т-лимфоциты
Обеспечение реакций клеточного
иммунитета; участие в реакциях
гумораного иммунитета
Цитотоксические Тлимфоциты (киллеры)
Тромбоциты
Иммуноглобулин
Вещества, которые контролируют
активность других лейкоцитов
(интерлейкины)
Уничтожение клеток опухоли или
клеток, инфицированных
вирусами
Вещества, которые уничтожают клетки
(перфорины)
Свертывание крови
Факторы свертывания крови
46. Лимфа
Лимфа (лат. lympha — влага) представляет собой слегка желтоватуюжидкость белковой природы, протекающую в лимфатических
капиллярах и сосудах. Она состоит из лимфоплазмы (plasma
lymphae) и форменных элементов. По химическому составу
лимфоплазма близка к плазме крови, но содержит меньше белков.
Функции лимфы
гомеостатическая – поддержание постоянства
микроокружения клеток путем регуляции объема и состава
интерстициальной жидкости;
метаболическая – участие в регуляции обмена веществ
путем транспорта метаболитов, белков, ферментов, воды,
минеральных веществ, молекул биологически важных
соединений;
трофическая – транспорт питательных веществ
(преимущественно липидов) из пищеварительного тракта в
кровь;
защитная – участие в иммунных реакциях (транспорт
антигенов, антител, лимфоцитов, макрофагов).
47. Кроветворение (гемопоэз)
Различают эмбриональный гемопоэз, который происходит вэмбриональный период и приводит к развитию крови как ткани, и
постэмбриональный гемопоэз, который представляет собой процесс
физиологической регенерации крови.
ГЕМОПОЭТИЧЕСКАЯ ТКАНЬ
Миелоидная
Лимфоидная
(ткань красного костного мозга)
(ткань лимфоидных органов)
Располагается в плоских костях,
эпифизах длинных трубчатых
костей
Располагается в тимусе,
селезенке, лимфатических узлах,
миндалинах, червеобразном
отростке
― Эритроциты
― Гранулоциты
― Моноциты
― Тромбоциты
― Т- и В-лимфоциты
― Плазматические клетки
48. Основные свойства полипотентных стволовых клеток крови:
Обладают способностью к самоподдержанию безпритока клеток извне (т.е. к образованию в
результате деления дочерних клеток).
Редко делятся (основное состояние – покоя).
Способны образовывать все виды форменных
элементов крови (т.е. обладают истинной
полипотентностью).
Устойчивы к действию повреждающих факторов (по
сравнению с более дифференцированными
клетками).
Располагаются в местах, хорошо защищенных от
внешних воздействий (ячейки в костной ткани) и
обладающих обильным кровоснабжением.
Циркулируют в крови, мигрируя в другие органы
кроветворения.
49. Дифференциация полипотентных стволовых клеток в ходе кроветворения
50. ЭРИТРОПОЭЗ
Процесс дифференцировки предшественниковэритроцита в зрелые форменные элементы
включает:
уменьшение размеров клетки;
выработку и накопление гемоглобина в цитоплазме;
постепенное снижение содержания и в конечном итоге
утрату всех органелл;
изменение окраски цитоплазмы от интенсивно
базофильной (в связи с большим числом
полирибосом) до оксифильной (обусловленной
присутствием гемоглобина);
снижение, а в дальнейшем – утрату способности к
делению;
конденсацию ядра и его последующее удаление из
клетки.

medicine
medicine








